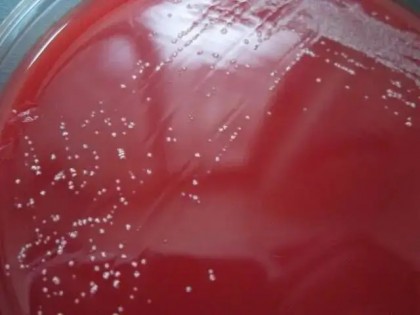

-
2022-12-05 11:21食品
上市即巅峰,赤藓糖醇龙头滨州三元生物净利润三连降,市值蒸发超百亿“0糖”饮料的浪潮匆匆涌过,带走了三元生物(301206.SZ)身上用泡沫堆砌的海市蜃楼。
-
2022-12-04 19:33食品
莱茵生物:与江南大学签订罗汉果甜苷微生物合成制造关键技术开发合同莱茵生物公告,公司与江南大学签订了《天然甜味剂微生物合成制造关键技术开发合同》,双方就罗汉果甜苷等天然甜味剂多个成分的微生物高效合成技术开发达成合作并签订了相关协议。江南大学负责构建可以从头合成罗汉果甜苷等天然甜味剂成分的工程菌株,
-
2022-12-03 13:37食品
2022年,安徽天凯生物DHA藻油相继通过美国GRAS、美国有机农业和欧洲素食认证天凯生物的持续努力得到了多方的认可,其DHA藻油相继通过美国GRAS、美国有机农业(USDA ORGANIC)和欧洲素食(V-Label)认证。接下来,让我们一起来了解下吧。
-
2022-12-02 13:20教育科研
华南理工黄明涛教授等:溶组织梭状芽孢杆菌胶原蛋白酶的研究进展华南理工大学食品科学与工程学院的肖 寒、刘秀妨、黄明涛*等在国内外最新研究进展的基础上,对溶组织梭状芽孢杆菌胶原蛋白酶的结构特征、水解机理、生产现状和实际应用等进行归纳总结,并对其未来的研究方向进行展望,以期能够为微生物源胶原蛋白酶的进一步开发和利用提供参考依据。
-
2022-12-01 15:19教育科研
戴晓虎教授团队:甾体类药物发酵菌渣的无害化与资源化研究进展目前已有的药物菌渣无害化与资源化技术中:填埋处置浪费资源,并且不适合大规模地处置药物菌渣;焚烧处理成本较高,且易引发二次污染问题;厌氧消化技术虽然高效但会增加污水处理压力;好氧发酵研究主要集中在抗生素菌渣处理,对甾体药物菌渣的研究鲜有报道。因此针对大量甾体药物菌渣的无害化处理与安全利用难题,亟待进一步研究开发高效的菌渣处理工艺,寻找安全利用的有效途径。
-
2022-12-01 14:28农业
11月维生素市场延续弱势运行据生意社大宗榜数据显示,11月国内维生素市场出现不同整体走低,部分产品价格进一步触底,其中维生素A和维生素C价格进一步走低,维生素E价格相对坚挺。
-
2022-12-01 14:12教育科研
昆明植物所实现植物药可卡因的从头生物合成记者11月29日从中国科学院昆明植物所获悉,该所在植物药可卡因的生物合成研究方面取得重要进展。相关研究成果以封面文章形式发表在国际期刊《美国化学学会杂志》上。
-
2024-12-27 13:13食品
四川「合泰新光」:专注研发创新生物多糖四川合泰新光生物科技有限公司(下称“合泰新光”)是一家专门从事生物多糖开发的国家级高新技术科研企业,凭借独特的知识产权技术、研发能力和生产平台,以研发创新生物多糖为主要目标,开发有助于人类健康的新食品原料、功能性免疫增强材料、动物饲料添加剂、化妆品原料和生物医用原料。
-
2022-11-30 13:40化工
烟台丰金生物透明质酸和聚谷氨酸项目预计明年下半年投产2021年12月,投资 6亿元的丰金医美项目也乘势开工,项目主要建设医美产品、生物发酵类原辅料、护肤品等70余条生产线,形成年产医美产品2000万支、化妆品原料级透明质酸和聚谷氨酸50吨,药用级透明质酸20吨以及功能性护肤品2亿支的生产能力,打造一座名副其实的“美丽工厂”。预计今年年底可完成基础设施建设,明年下半年投入生产。
-
2022-11-30 11:27化工
第十一届中国工业生物技术发展高峰论坛暨第六届生物工业投资大会线上举办昨天,由中国科学院科技促进发展局、中国生物工程学会主办,中国科学院天津工业生物技术研究所、中科育成(天津)科技发展有限公司联合有关单位承办的“第十一届中国工业生物技术发展高峰论坛暨第六届生物工业投资大会”开幕。本次大会以“创建细胞工厂,发展生物经济”为主题,围绕“双碳”背景下,生物制造支撑生物经济高质量发展的战略任务和方向路径,展开充分交流研讨
-
2022-11-30 10:55教育科研
中美科学家联手发现溶木聚糖拟杆菌通过降解肠道尼古丁降低脂肪肝发病率在一项新的研究中,来自中国北京大学、浙江大学、复旦大学、温州医科大学和美国国家癌症研究所的研究人员在小鼠肠道中分离出了一种能够分解尼古丁的细菌。相关研究结果近期发表在Nature期刊上。
-
2022-11-29 13:47化工
山西锦波生物重启IPO,重组胶原蛋白成资本新宠此前,锦波生物在中信证券股份有限公司的辅导下,已通过中国证券监督管理委员会山西监管局的辅导验收,并在5月27日向北交所报送了相关申报材料。 5月30日,公司股票在全国中小企业股份转让系统(即“新三板”)停牌。6月6日,公司收到了北交所出具的《受理通知书》。北交所正式受理公司向不特定合格投资者公开发行股票并上市的申请。但在9月29日,因公司需更新招股说明书中引用的财务资料,而相关财务数据更新工作尚在准备过程中,锦波生物向北交所提交了关于中止审核的申请,北交所在业务系统中将锦波生物本次公开发行股票并在北
-
2022-11-29 12:15食品
青岛荣盛微藻生物科技—养殖高品质雨生红球藻粉 不断开拓虾青素终端产品市场荣盛微藻根植于华盛绿能大农业产业平台,以健康产业为依托,在持续养殖高品质雨生红球藻粉的同时,不断开拓虾青素终端产品市场,为客户持续提供全系列的产品解决方案,通过不懈努力推动大健康产业的发展和进步。
-
2022-11-29 10:06医药
核酸企业IPO“从严审核”第一枪:翌圣生物突遭取消审议,业绩持续性成疑除翌圣生物的上市审核被取消外,菲鹏生物的创业板IPO似乎也遇到了“瓶颈”,其上市审核早在今年3月3日便已过会,并在3月14日提交注册申请,但到目前为止仍未获批。
-
2022-11-28 09:14食品
肌氨酸钠应用领域广泛 但生产工艺有待改进新思界行业分析人士表示,肌氨酸钠在日化用品、保健品、制药等领域应用广泛,随着颜值经济崛起、消费升级,肌氨酸钠市场需求将增加,行业发展前景较好。我国是肌氨酸钠生产大国,但目前国内肌氨酸钠生产工艺仍存在问题,在工业结构转型背景下,肌氨酸钠生产工艺有待改进。
-
2022-11-25 14:32农业
2022年10月我国赖氨酸、苏氨酸出口量同比下降据海关数据统计,2022年10月,我国赖氨酸与赖氨酸盐及酯的出口量为7.4万吨,环比增15%,同比降4.3%。2022年1-10月,我国赖氨酸盐及酯出口量共80.74万吨,同比增25%。2022年国内赖氨酸盐及酯对外主要出口国有荷兰、德国、泰国、越南、俄罗斯联邦、美国、波兰、丹麦、立陶宛、加拿大、印度等。
-
2022-11-25 13:07医药
尚有相关事项待核查 上海翌圣生物IPO上会取消据了解,翌圣生物原定于11月25日上会,公司主要从事分子类、蛋白类和细胞类生物试剂的研发、生产与销售,报告期内新冠产品相关收入对公司营收贡献度显著上升。
-
2022-11-25 10:53医药
湖南津市生物医药产业园规模初具津市市委、市政府坚持科技是第一生产力、人才是第一资源、创新是第一动力,不断塑造发展新动能新优势。构建以生物医药为主导、绿色精细化工为特色的产业格局,促进产业链向中高端迈进。
-
2022-11-22 22:08食品
尚科生物:情况说明—针对FDA对我司NMN原料的NDI撤回通知函尚科生物除了继续完成NMN在产能和质量上的持续提升外,也在积极寻求全球的产品认证,包括中国、北美、日韩、欧盟、澳洲等国家和地区的一系列合规认证。
-
2022-11-22 22:03农业
钱江生化:拟3.5亿元全资设立启潮生物 优化资源配置 推动转型发展11月22日晚间公告,公司拟以自有资金3.5亿元投资设立全资子公司浙江启潮生物科技有限公司,将原位于浙江省海宁市的生产基地整体搬迁,其原农药、饲料、肥料等生产、经营管理业务划入启潮生物。
-
2022-11-20 14:03教育科研
大连化物所周雍进团队实现以葡萄糖为原料高效合成香紫苏醇 产量达到11.4g/L近日,中科院大连化学物理研究所研究员周雍进团队在天然产物萜类合成生物学研究中取得新进展。该团队在酿酒酵母中构建并优化了二萜香紫苏醇生物合成途径,通过全局调控中心代谢途径,实现了香紫苏醇的高效合成。相关成果发表于《代谢工程》。
-
2022-11-18 16:23医药
苏州富士莱:硫辛酸特色原料药全球龙头 另有磷脂酰胆碱、肌肽两大系列产品硫辛酸具有很强的抗氧化功效,常被用于药品和保健品,海外需求持续旺盛。在医药领域,硫辛酸注射液已成为各大权威指南一致推荐的糖尿病神经病变治疗药物。根据药智数据,全球硫辛酸系列产品的市场容量预计超过1200 吨/年。全球的硫辛酸基本由国内厂商供应,而国内行业CR2近年维持在80%左右,行业集中度很高,竞争格局良好且稳定。 随着保健品行业发展和硫辛酸渗透率的提升,细分市场稳定增长。根据 gminsight 的数据,2020年硫辛酸市场规模为8.06亿美元,预计从2021年将以6.3%的复合年增长率增长,在20
-
2022-11-18 16:16医药
苏州富士莱研究报告:硫辛酸特色原料药全球龙头,新业务加速拓展公司自 2000 年设立起即开始从事硫辛酸系列产品的研发、生产和销售,已成为全球硫辛酸产品 的重要供应商。公司是国内最早生产硫辛酸系列产品的企业之一,随着多年经营积累和持续的技 术创新,硫辛酸系列产品已远销欧洲、美国、韩国、日本、印度等海外主要市场。公司业绩快速成长,主要由硫辛酸系列产品销售增长带动。公司营业收入从 2013 年的 1.67 亿元 增长到 2021 年的 5.22 亿元,13-21 年复合增速为 15.31%,22H1 营业收入达到 2.72 亿元,同比 +5.79%。
-
2022-11-18 15:18教育科研
L-半胱氨酸高通量筛选平台开发取得进展中国科学院天津工业生物技术研究所研究员刘君带领的微生物生理和代谢工程研究组,利用响应L-半胱氨酸的转录调控因子,开发了L-半胱氨酸生物传感器,并建立了L-半胱氨酸高通量筛选平台。相关研究成果发表在Metabolic Engineering上。
-
2022-11-18 14:22农业
在供应紧张和需求旺盛的双重压力下,酒石酸泰乐菌素市场均价再次走高对于下半年酒石酸泰乐菌素价格持续走高,中国兽药饲料交易中心分析师表示,一方面,酒石酸泰乐菌素作为制备替米考星等原料药的中间体,被大量使用,直接面向市场货源减少;另一方面部分主流厂家,生产不畅,接发不顺,供应压缩。双重因素影响下,酒石酸泰乐菌素整体供应呈现偏紧态势。
-
2022-11-18 14:15医药
辽宁本溪红球生物诺卡氏菌药物全智能生产基地项目加紧建设11月15日上午,记者在本溪高新技术产业开发区生物医药产业园建筑工地看到,现场塔吊林立、机器轰鸣,红球生物全智能生产基地项目工程正加紧建设。
-
2022-11-16 14:03农业
硕腾中国生物制药制造基地和研发中心在苏州开业11月15日,全球领先的动物保健公司硕腾在苏州举办硕腾中国生物制药制造基地和研发中心(硕腾生物制药有限公司)开业活动,并宣布首批商业化国产猫用疫苗妙三多®在苏州正式供应上市,标志着硕腾中国本土化生产迈出关键性的一步。
-
2022-11-15 11:01化工
广济药业:与北京蓝晶微生物公司就合成生物学领域达成战略合作关系广济药业与北京蓝晶微生物科技有限公司(“北京蓝晶”)于2022年11月签署《战略合作框架协议》。
-
2022-11-09 22:10医药
南京诺维赞 曹林:热血寻“酶”,让世界看到中国“生物芯片”2012年,曹林联合师兄弟创立诺唯赞,一头闯入生物科研试剂领域。面对拥有雄厚技术、高品质产品、广泛销售渠道的国际巨头,这只“初生牛犊”脚踏荆棘,始终坚持原始创新,致力于攻坚多项国际高端酶、抗原抗体“卡脖子”技术。
-
2022-11-08 22:53农业
远大控股拟逾8亿收购麦可罗生物,持续深耕生物农业领域远大控股(000626.SZ)近日发布公告称,其全资子公司远大生态科技(宁波)有限公司拟采用支付现金方式收购翁婧等5位转让方持有的陕西麦可罗生物科技有限公司合计100%股权,标的股权作价8.3亿元,实际支付转让方对价不超过7.8亿元,其余约0.5亿元最终支付给标的公司,增强其运营能力。
发酵工业网手机版
打开微信右上角添加朋友中搜索公众号“发酵工业”,关注即可随时随地使用发酵工业服务。发酵工业微信更省心!






